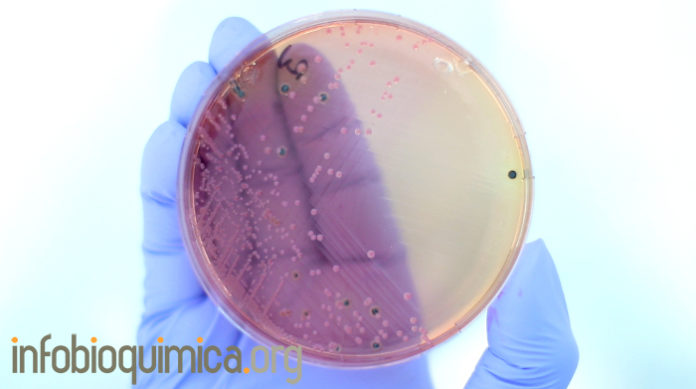

Dentro de la práctica rutinaria diaria, el laboratorio de microbiología aplica técnicas fenotípicas que permiten lograr este objetivo. Sin embargo, muestran algunas limitaciones que se observan de manera más evidente para algún tipo de microorganismo.
Los métodos moleculares permiten soslayar algunas de estas limitaciones, si bien su implementación no es universal. Este hecho se debe a un coste más elevado y al grado de especialización que se requiere para su aplicación, por lo que los métodos moleculares suelen estar centralizados en laboratorios o centros de referencia.
Recientemente los métodos basados en proteómica han irrumpido de manera importante en el campo del diagnóstico microbiológico y sin duda va a tener un gran impacto en la organización futura de los servicios de microbiología.
Este manuscrito revisa de manera concisa los aspectos más reseñables de los tres métodos de identificación bacteriana arriba descritos que se usan en los laboratorio de microbiología.
Autores: Germán Boua, Ana Fernández-Olmosb, Celia Garcíac, Juan Antonio Sáez-Nietod, Sylvia Valdezated
- Servicio de Microbiología, Complejo Hospitalario Universitario, La Coruña, España
- Servicio de Microbiología, Hospital Ramón y Cajal, Madrid, España
- Servicio de Microbiología, Hospital Universitario Marqués de Valdecilla, Santander, España
- Servicio de Bacteriología, Centro Nacional de Microbiología, Instituto de Salud Carlos III, Majadahonda, Madrid, España